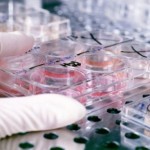
Becas de movilidad José Castillejo para jóvenes doctores

Más que un derecho, la educación se ha convertido en todo un lujo. Estudiar en determinados centros académicos o en el extranjero es una experiencia a la que algunas personas no pueden tener acceso. Sin embargo, son muchas las universidades, instituciones y centros académicos que ponen a disposición de todos aquellos interesados, una amplia oferta de becas y ayudas para los estudiantes con talento y ganas de aprender.
Este es el caso de la Universidad Estadual Paulista de Brasil (UNESP) que convoca un amplio programa de becas para estudiantes extranjeros que quieren cursar estudios de doctorado en este centro académico. En total se ofrecen 20 becas que tienen una duración de 48 meses, y que están dirigidas a profesores e investigadores no brasileños, de instituciones y centros de educación superior, procedentes de cualquier país iberoamericano, además de España y Portugal.
Así que se reúnes todas estas cualidades y te apetece continuar con tu formación en el extranjero, no te lo pienses más y participa en esta increíble experiencia. Puedes consultar en tu centro académico o en la Universidad Estadual Paulista de Brasil, a través de la página Web oficial, www.unesp.br.
El programa de becas está dirigido a una amplia variedad de ámbitos académicos, como biología, agronomía, diseño, comunicación, física, química, ingeniería, geografía, medicina, letras, historia y magisterio, entre otras muchas especialidades más.
La oportunidad que estabas buscando para especializarte en un campo y vivir una temporada en el extranjero. Prepárate para descubrir otras culturas y estilos de vida, y conocer gente interesante, además de hacer importantes contactos profesionales y ampliar tu currículum vitae. Una oportunidad única en la vida, de esas que no se presentan todos los días, así que no la dejes pasar y solicita información en la Universidad Estadual Paulista de Brasil.